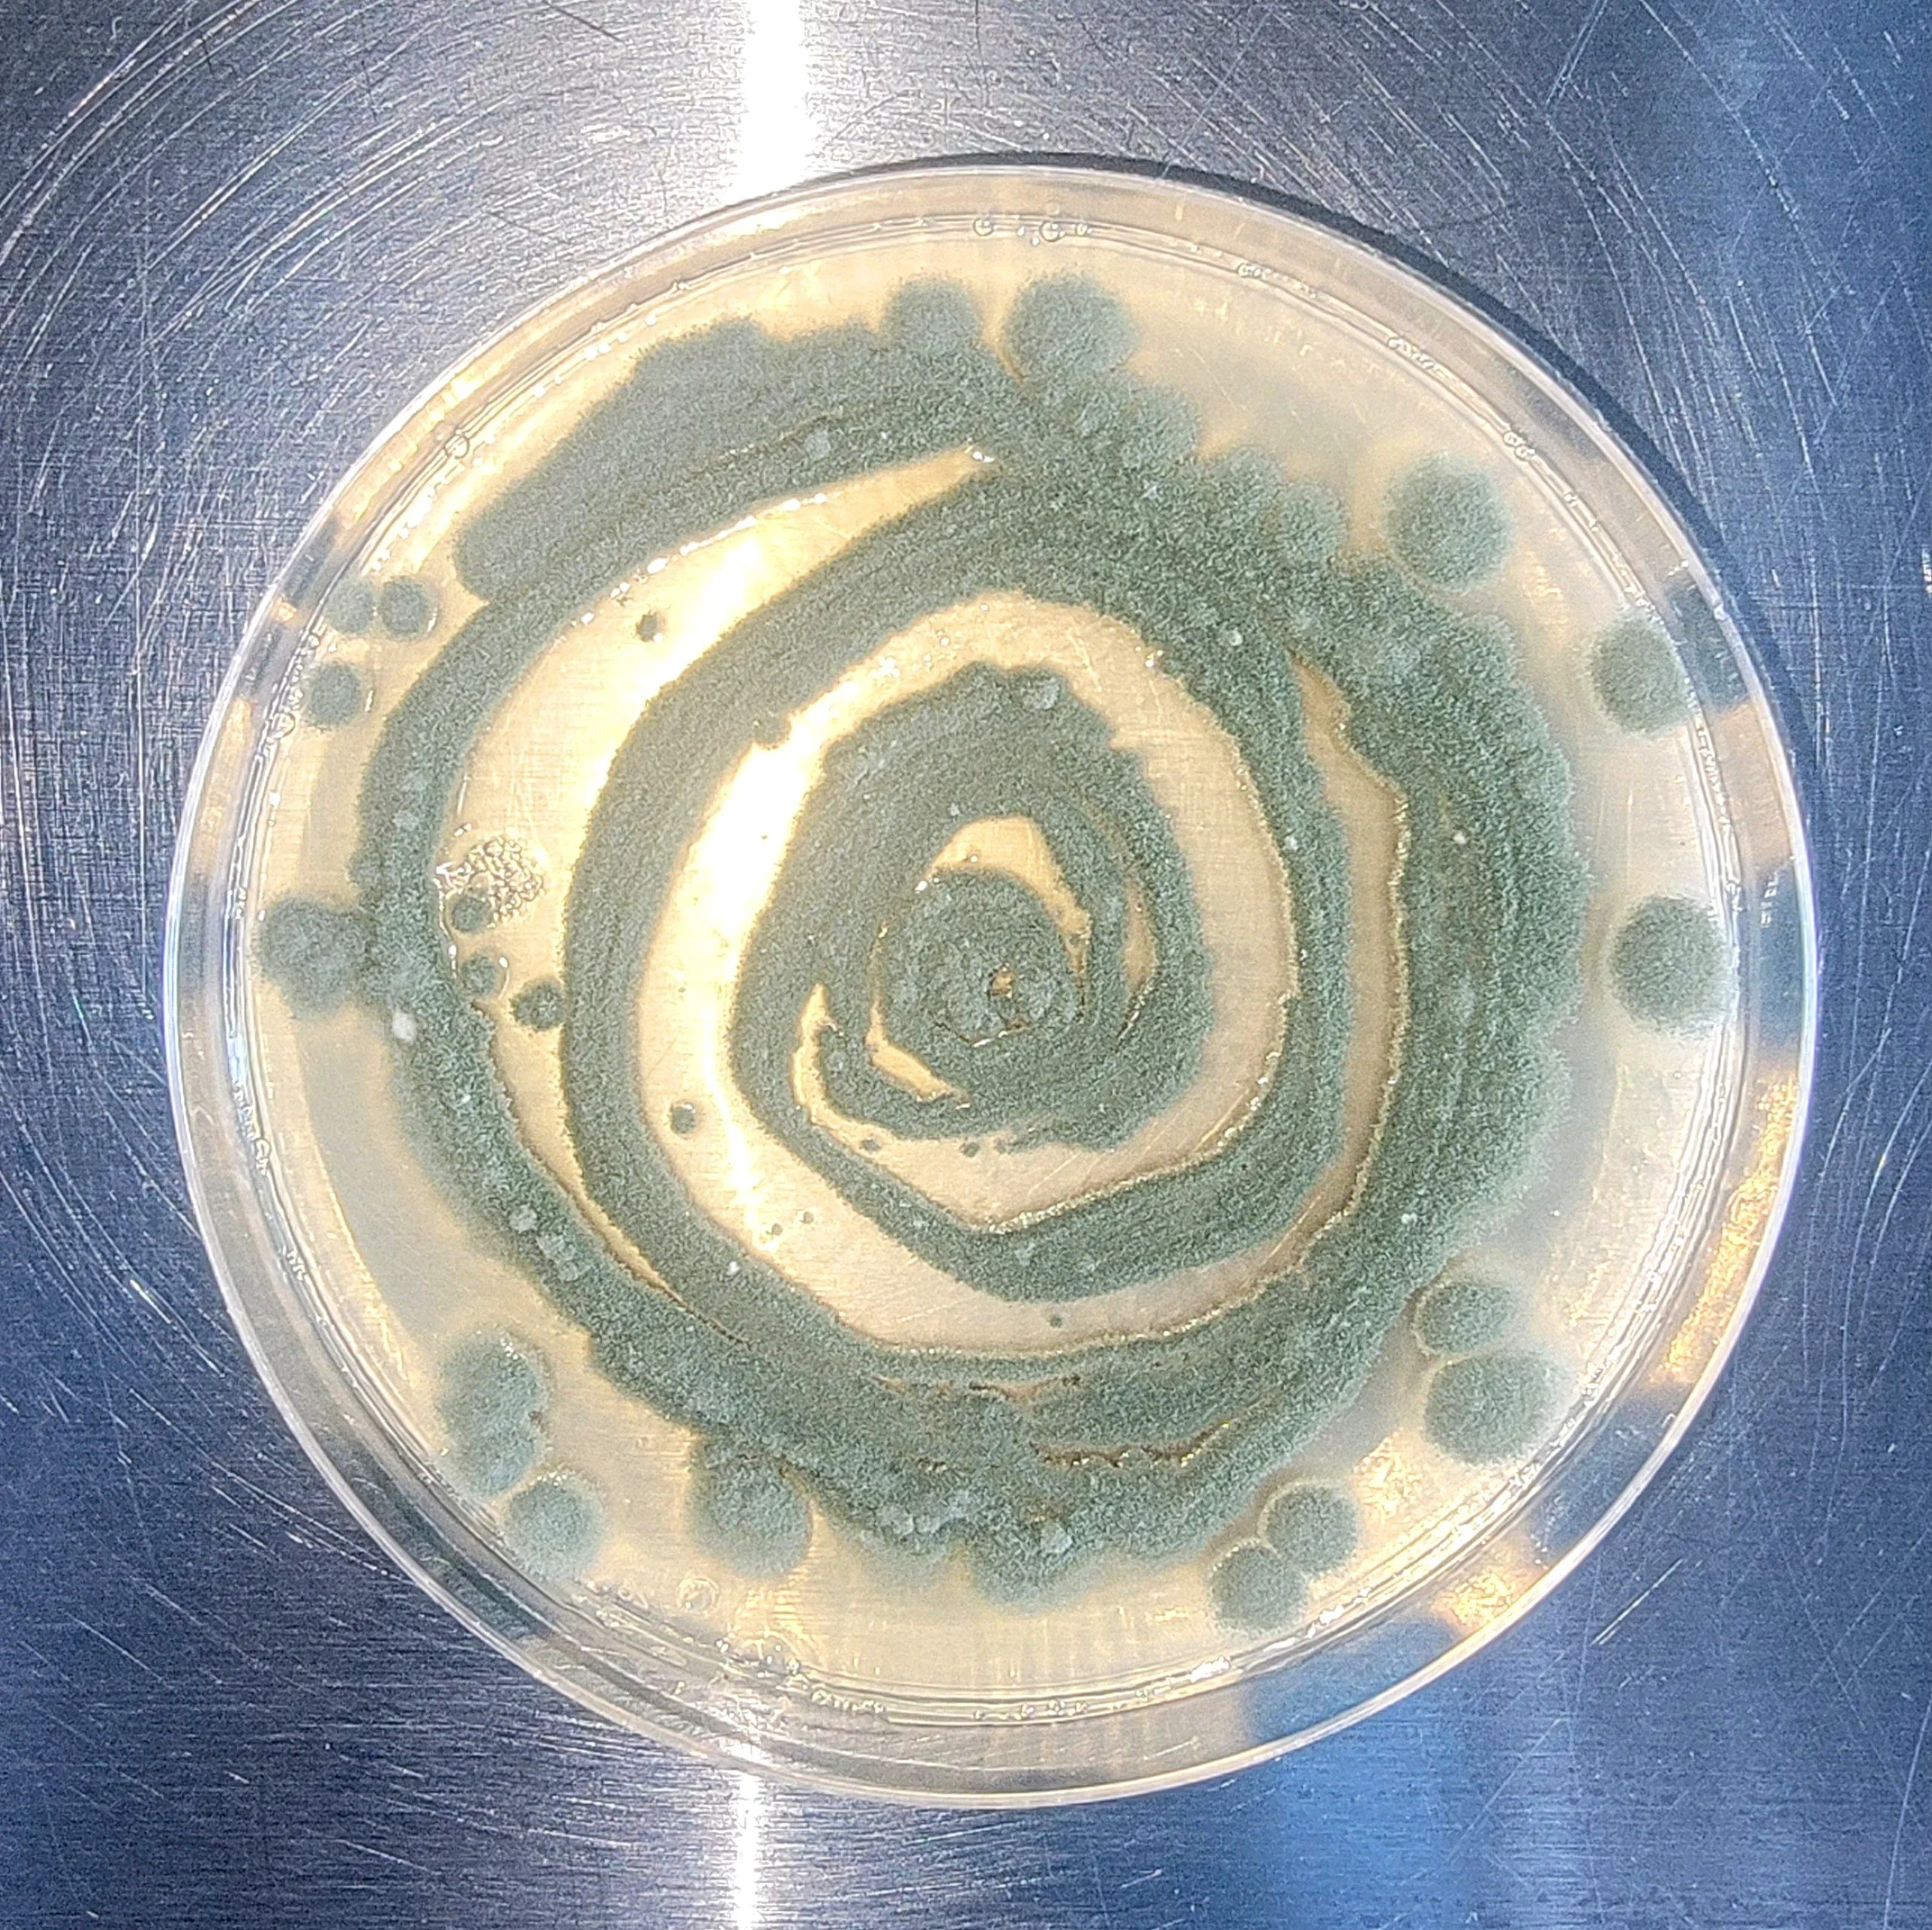

Studio Practice
This Blog Digitally Archives documentation of my studio practices, collaborative projects, commissioned work, and other musings that help me slowly make sense of things.
- Enjoy

Passengers by MOLD
MOLD, a nomadic gallery, presents Passengers, an exhibition highlighting the work of designers and artists

Material Assemblages: before and after the Human

Sketching in Hardware 2025 @ Paris Fr.

Hexagram Gala Exhibition

Aujourd'hui je pleure parce que @ Pangée Gallery

La création au-delà de l'humain - Toulouse Fr

Mona Antabli + Sainte Vierge : Biopolymer-Composite Textile

PBGS sequence of TCHH gene, woven with my own hair

laser engraved balistic nylon on stainless steel

3d printed tpu scaffold coated in polymer hydrogel

a variety of PBGS printing and weaving tests


PBGS laser projected on my Tattoos (@AvantGardener)
-
During my BFA in Fiber Arts and Material Practices, I gained comprehensive technical skills in weaving, spinning, knitting, crochet, synthetic+natural dye, felting, and surface design, while also experimenting with unconventional materials and conceptual integration. The program deepened my conceptual understanding through hand-on craftmanship and the historical and theoretical origins of Fiber art
-
-
-
Item description